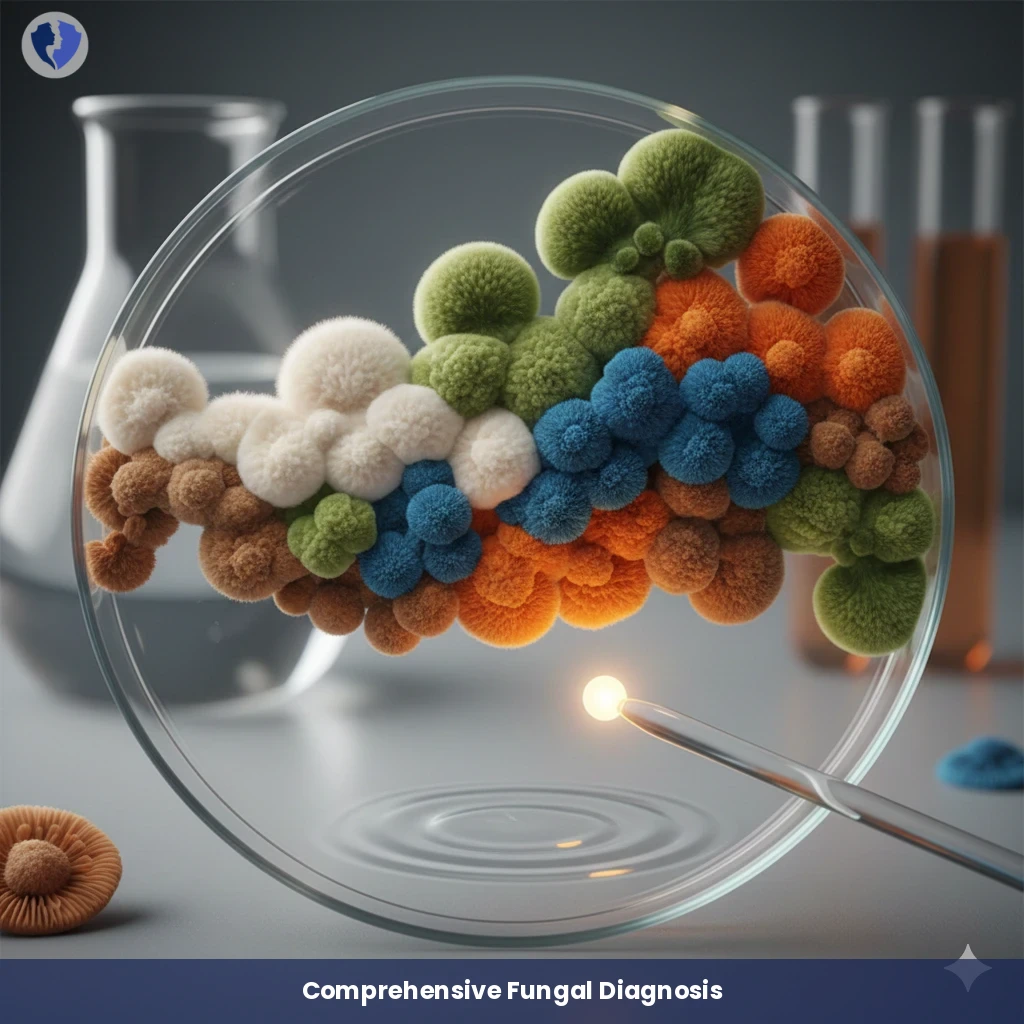
Identify Fungal Species - Fungal Culture and Sensitivity Test

Service Details
Identify Fungal Species - Fungal Culture and Sensitivity Test
A specialized microbiological test involves culturing a clinical sample (blood, skin, deep tissue, sterile fluids, etc.) on a fungal culture medium (such as saporo dextrose agar). The aim is to isolate and identify the fungi causing the infection (yeasts or filamentous fungi). The test includes antifungal susceptibility testing to determine the most effective drug for treating the infection, particularly in severe cases or in immunocompromised patients.